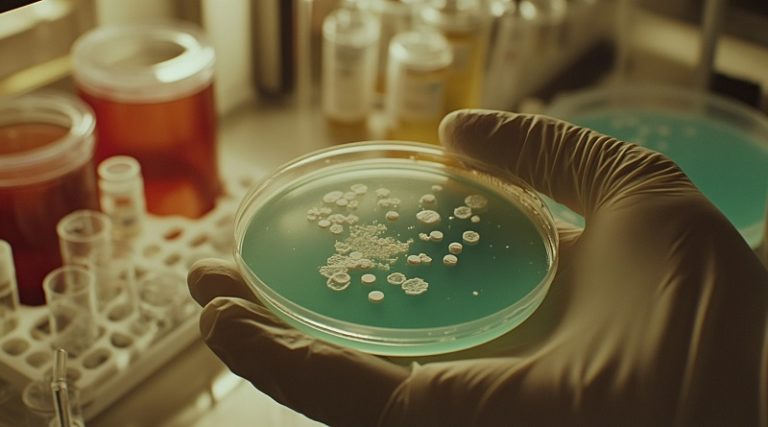

CIUDAD MCY.- La Inteligencia Artificial generativa (GenAI, por sus siglas en inglés) podría convertirse en una aliada clave para combatir una de las mayores amenazas para la salud global: la resistencia a los antibióticos. Un nuevo estudio, publicado esta semana, presenta una herramienta de IA bautizada como AMP-Diffusion que es capaz de diseñar moléculas antibacterianas inéditas, con potencial terapéutico probado en modelos animales.
El trabajo es fruto de la colaboración entre los laboratorios de Pranam Chatterjee y César De la Fuente, un especialista en diseño molecular y el segundo en Inteligencia Artificial aplicada a la búsqueda de nuevos antibióticos. Mientras que investigaciones previas habían demostrado que la IA puede analizar grandes cantidades de datos para encontrar candidatos prometedores, este estudio da un paso más allá: crear desde cero moléculas que la naturaleza nunca ha producido.
“El conjunto de datos de la naturaleza es finito; con la IA podemos diseñar antibióticos que la evolución nunca intentó”, afirmó De la Fuente, profesor en Bioingeniería, Ingeniería Química y Biomolecular, Psiquiatría y Microbiología en la universidad estadounidense.
Por su parte, el profesor en Bioingeniería e Informática Chatterjee, añadió que “estamos aprovechando los mismos algoritmos de IA que generan imágenes, pero adaptándolos para diseñar nuevas moléculas potentes”.
De ruido a moléculas antibacterianas
AMP-Diffusion utiliza un tipo de IA conocido como modelo de difusión, el mismo principio que emplean herramientas como DALL·E o Stable Diffusion para crear imágenes a partir de los prompts que los usuarios introducen. En lugar de “desenmascarar” píxeles, este modelo refina secuencias de aminoácidos hasta obtener péptidos con potencial antimicrobiano.
“Es casi como sintonizar la radio”, señaló De la Fuente. “Empiezas con sonido estático y, finalmente, emerge la melodía”. La clave está en su integración con ESM-2, un modelo de lenguaje para proteínas desarrollado por Meta y entrenado con cientos de millones de secuencias naturales. Gracias a esta base, la herramienta no necesita aprender desde cero las reglas de la biología, lo que acelera el diseño y aumenta la probabilidad de éxito de las moléculas generadas.
Fuente: SINC